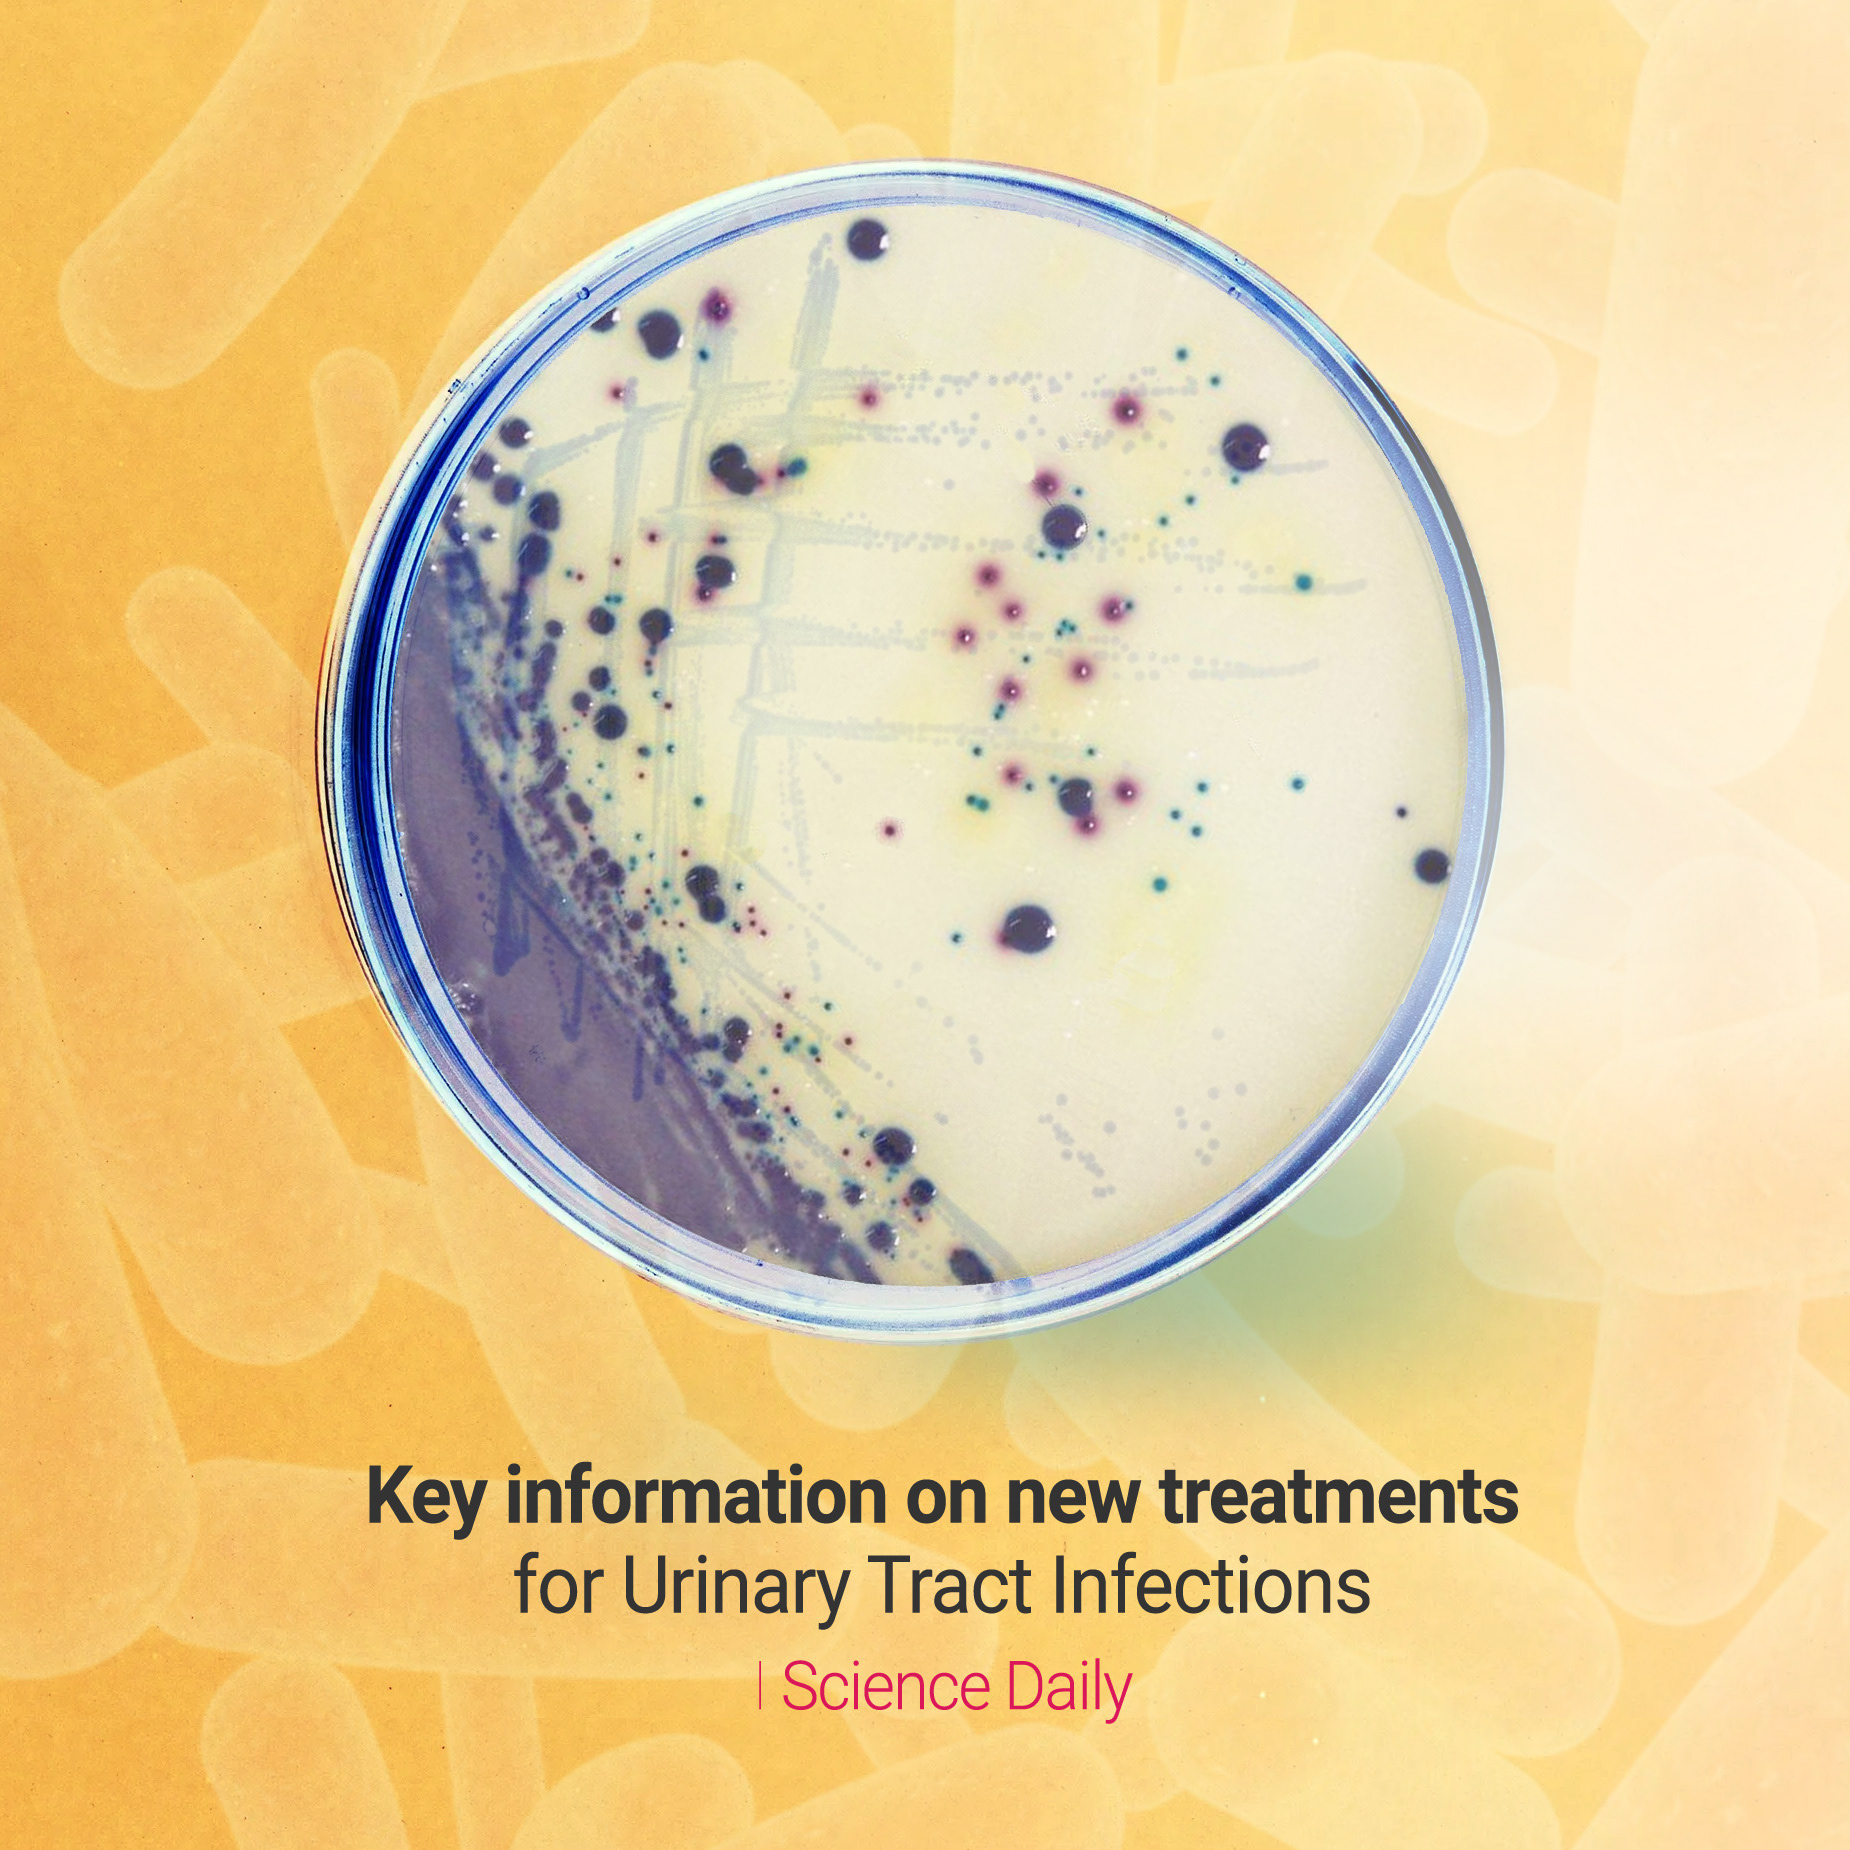

CLIENT ▸ Science Direct
ROLE ▸ Graphic Design, Illustrator
SCOPE ▸ Digital Assets, Social Posts, Campaign Materials
ROLE ▸ Graphic Design, Illustrator
SCOPE ▸ Digital Assets, Social Posts, Campaign Materials
The Challenge
Create high-clarity social graphics for a science-focused audience without oversimplifying the content
Maintain visual consistency across a stream of posts while working within an existing brand system
Design assets that perform at-feed: legible, scroll-stopping, and information-forward
Create high-clarity social graphics for a science-focused audience without oversimplifying the content
Maintain visual consistency across a stream of posts while working within an existing brand system
Design assets that perform at-feed: legible, scroll-stopping, and information-forward
Strategic Approach
Treat social as a modular content system: repeatable templates, consistent hierarchy, fast production
Prioritize readability first (type scale, contrast, spacing) to support dense or technical messaging
Establish a flexible layout logic that accommodates different post types (announcements, highlights, quotes, stats)
Treat social as a modular content system: repeatable templates, consistent hierarchy, fast production
Prioritize readability first (type scale, contrast, spacing) to support dense or technical messaging
Establish a flexible layout logic that accommodates different post types (announcements, highlights, quotes, stats)
Creative Solution
A clean, structured set of social post designs aligned to the existing ScienceDirect brand guidelines
Visual rhythm built through consistent typography, spacing, and compositional rules
Graphics optimized for quick comprehension and reliable series-level cohesion
A clean, structured set of social post designs aligned to the existing ScienceDirect brand guidelines
Visual rhythm built through consistent typography, spacing, and compositional rules
Graphics optimized for quick comprehension and reliable series-level cohesion
Scope & System
Template-driven layout system to support volume and speed
Defined hierarchy for headline, subhead, metadata, and CTAs
Modular components (type blocks, rules, containers) enabling variation without visual drift
Format considerations for social placements and responsive cropping
Template-driven layout system to support volume and speed
Defined hierarchy for headline, subhead, metadata, and CTAs
Modular components (type blocks, rules, containers) enabling variation without visual drift
Format considerations for social placements and responsive cropping
Key Results
Consistent, recognizable social outputs across multiple posts
Improved legibility and message clarity at-feed
A repeatable approach enabling faster content production without sacrificing quality
Consistent, recognizable social outputs across multiple posts
Improved legibility and message clarity at-feed
A repeatable approach enabling faster content production without sacrificing quality
Impact & Performance
Stronger content coherence across the social stream
Reduced friction for ongoing production through reusable layout logic
Increased confidence that scientific messages translate clearly in social environments
Stronger content coherence across the social stream
Reduced friction for ongoing production through reusable layout logic
Increased confidence that scientific messages translate clearly in social environments
Deliverables
+ Social media post designs (static)
+ Template-based layout variations for multiple content types
+ Export-ready assets for publishing
+ Social media post designs (static)
+ Template-based layout variations for multiple content types
+ Export-ready assets for publishing
Role & Leadership
Sr Brand Designer (Execution Within Existing System)
Directed high-volume social asset production within established brand parameters, optimizing clarity, consistency, and scalability.
Sr Brand Designer (Execution Within Existing System)
Directed high-volume social asset production within established brand parameters, optimizing clarity, consistency, and scalability.















Why This Works Matters
Science communication succeeds or fails on clarity.
These assets show how disciplined design systems can translate complex, information-rich content into social formats that people actually read, without compromising credibility.
Even without rebranding, strong design execution increases comprehension, consistency, and trust.
Science communication succeeds or fails on clarity.
These assets show how disciplined design systems can translate complex, information-rich content into social formats that people actually read, without compromising credibility.
Even without rebranding, strong design execution increases comprehension, consistency, and trust.

Need to make complex information
clear & engaging?
clear & engaging?

















